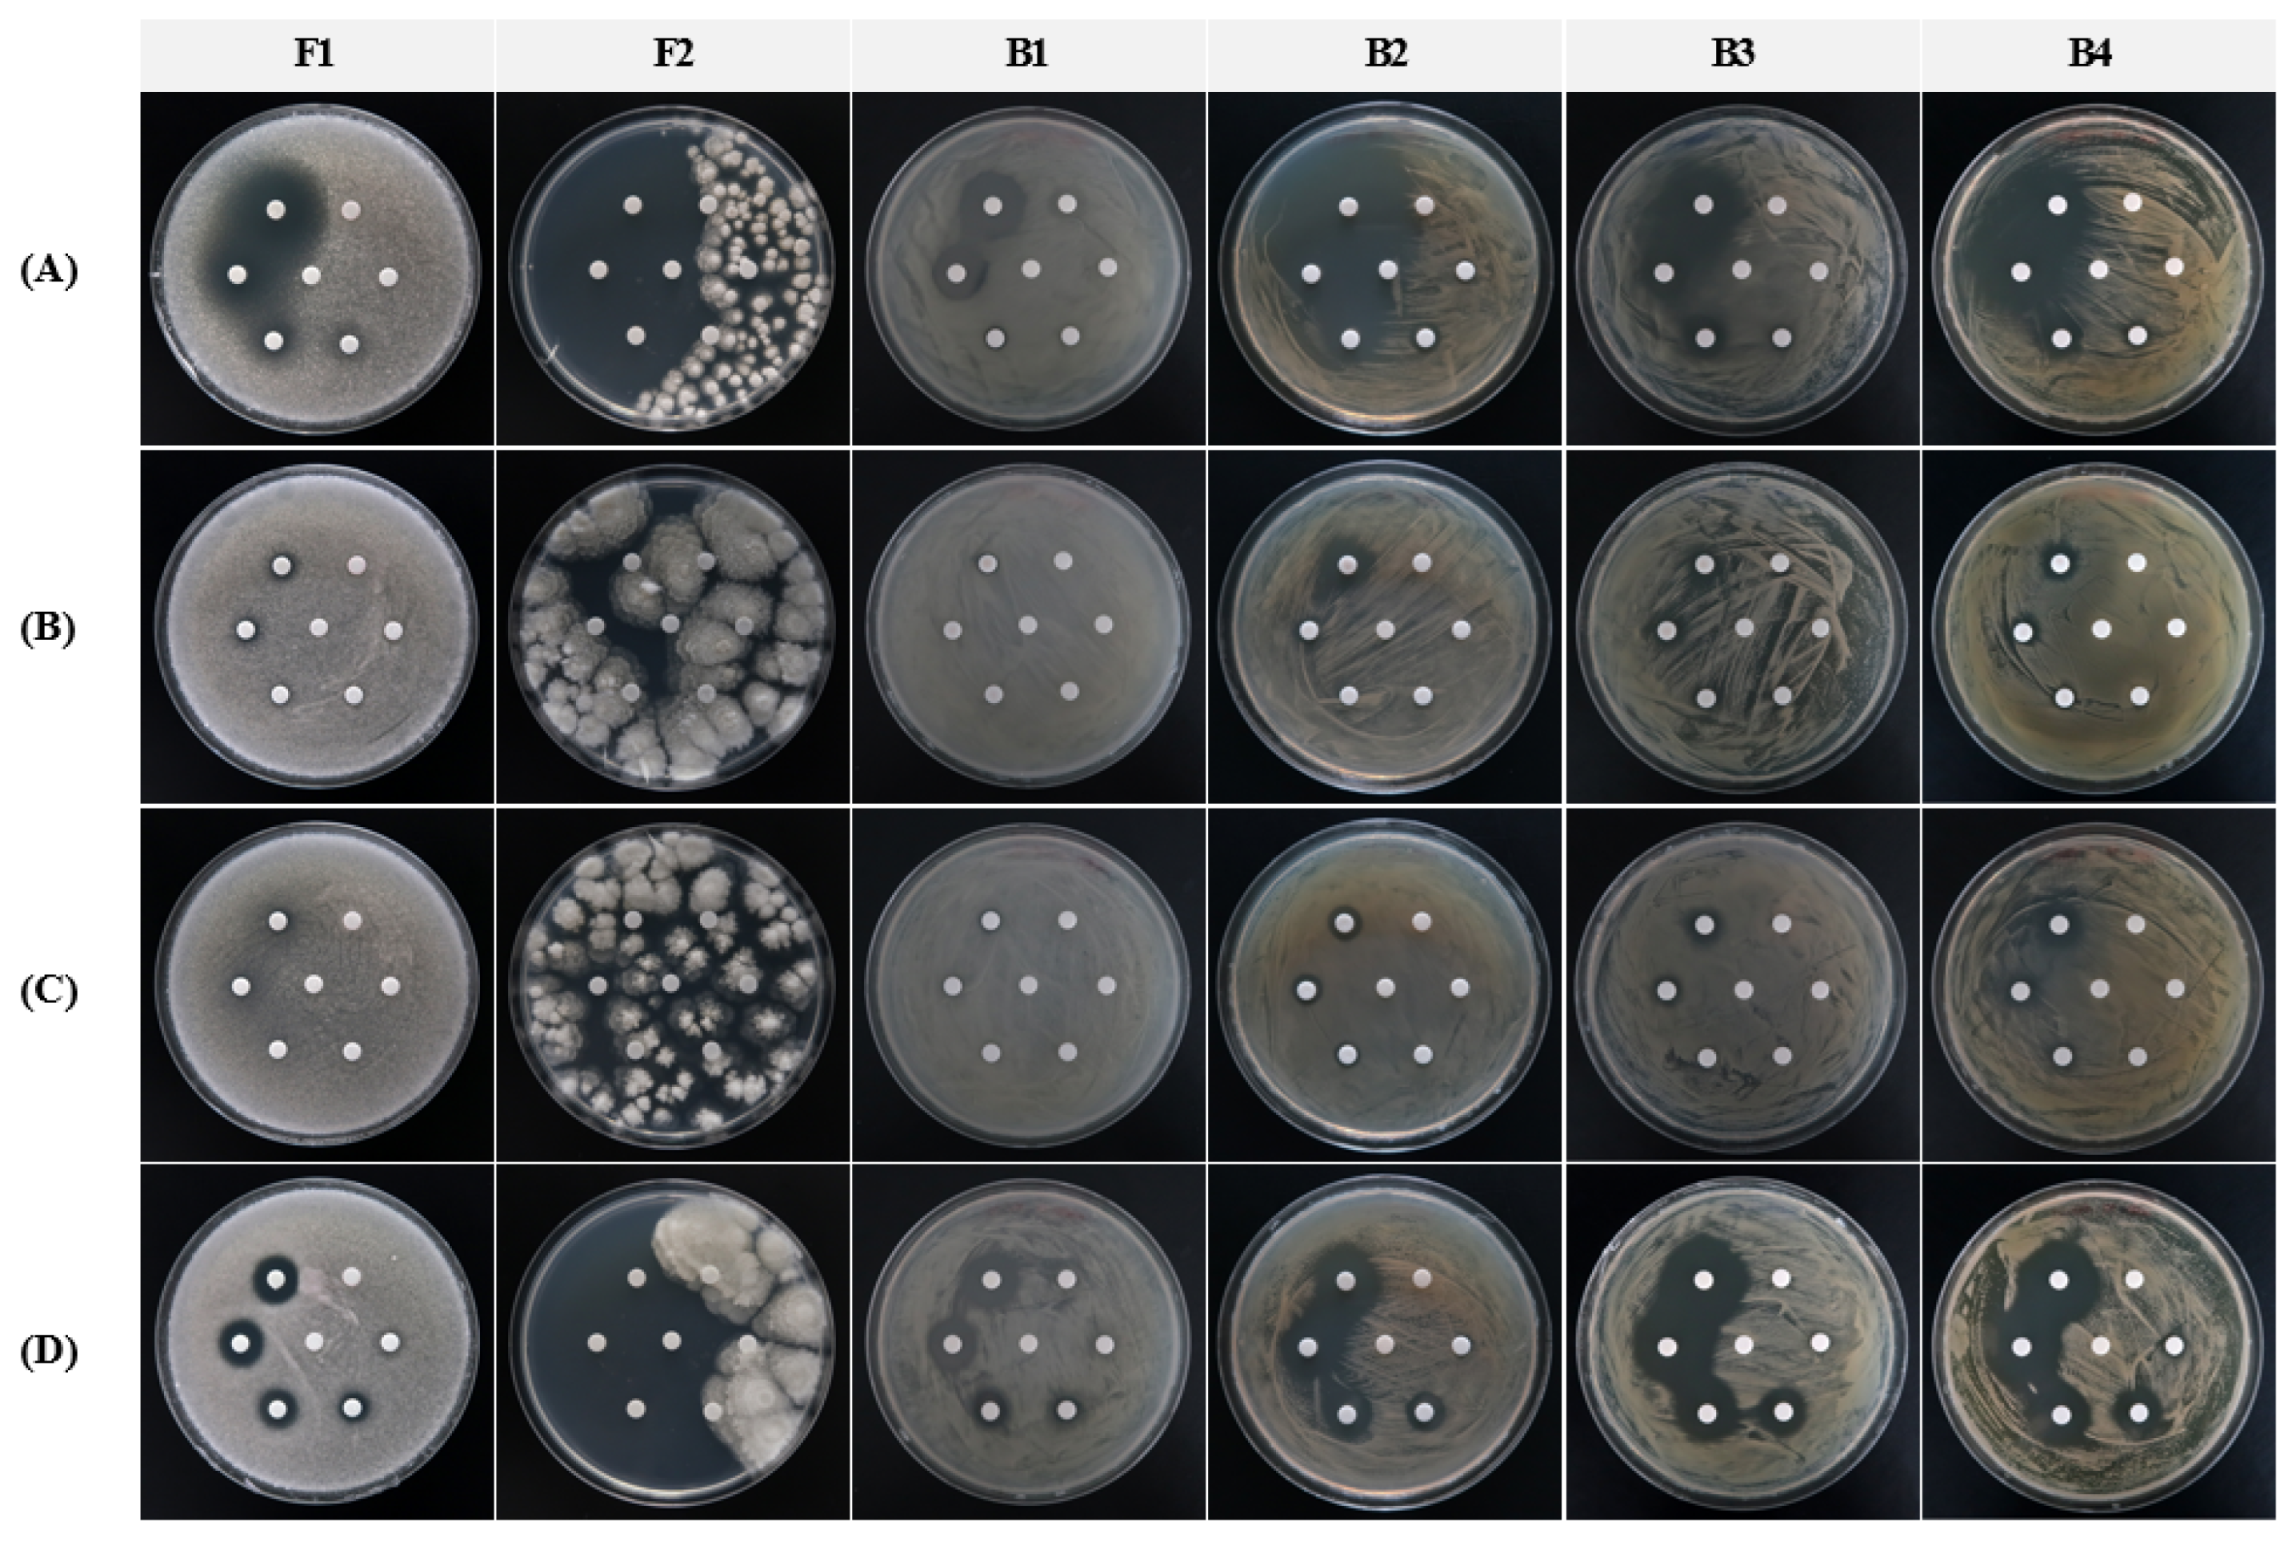
Applsci 13 03645 g003 Applsci 13 03645 g003

Antifungal, Antibacterial, and Interference Effects of Plant-Extracted Essential Oils Used for Mural Conservation at Buyeo Royal Tomb No. 1
Abstract
1. Introduction
2. Materials and Methods
2.1. Study Site
2.2. Microbial Growth Inhibition by Essential Oils
2.2.1. Selection of Standard Test Strains
2.2.2. Selection of Essential Oils
2.2.3. Measurement of Antifungal and Antibacterial Activities of Essential Oils
2.2.4. Measurement of Antifungal and Antibacterial Activities of Low-Concentration Essential Oils
2.2.5. Statistical Analysis
2.3. Interference Tests on Low-Concentration Essential Oils
2.3.1. Stability of Stone Materials under Treatment with Essential Oils
2.3.2. Stability of Painting Layers under Treatment with Essential Oils
3. Results
3.1. Microbial Growth Inhibition by Essential Oils
3.1.1. Antifungal Activity
3.1.2. Antibacterial Activity
| Source of EO | Inhibition Zone (mm) | |||||
|---|---|---|---|---|---|---|
| Strain F1 | Strain F2 | Strain B1 | Strain B2 | Strain B3 | Strain B4 | |
| Eucalyptus | - * | - * | - * | 1.0 ± 0.0 | 0.8 ± 0.0 | 1.0 ± 0.0 |
| Lavender | 0.3 ± 0.0 | - * | 0.8 ± 0.1 | 2.1 ± 0.2 | 4.3 ± 0.1 | 3.1 ± 0.4 |
| Tea tree | 0.3 ± 0.0 | - * | 0.8 ± 0.2 | 5.4 ± 0.1 | 5.3 ± 0.5 | 3.2 ± 0.2 |
| Peppermint | 0.4 ± 0.1 | 3.8 ± 1.2 | 0.9 ± 0.1 | 3.8 ± 0.0 | 4.0 ± 0.2 | 3.4 ± 0.3 |
| Oregano | 4.8 ± 0.2 | 19.3 ± 0.0 | 6.7 ± 0.9 | 19.3 ± 0.0 | 18.6 ± 0.5 | 18.4 ± 1.2 |
| Rosemary | - * | 1.0 ± 0.8 | - * | 1.1 ± 0.1 | 1.3 ± 0.2 | 0.9 ± 0.2 |
| Clove bud | 3.0 ± 0.0 | 19.3 ± 0.0 | 2.6 ± 0.0 | 9.0 ± 0.6 | 9.4 ± 1.5 | 6.8 ± 0.9 |
| Thyme | 4.3 ± 0.0 | 19.3 ± 0.0 | 7.5 ± 0.4 | 19.3 ± 0.0 | 19.3 ± 0.0 | 19.3 ± 0.0 |
| Grapefruit | - * | - * | - * | 0.3 ± 0.0 | 0.5 ± 0.0 | 0.6 ± 0.1 |
| Basil | 0.3 ± 0.0 | - * | - * | 1.9 ± 0.0 | 1.0 ± 0.1 | 2.6 ± 0.1 |
| Cinnamon cassia | 4.6 ± 0.1 | 19.3 ± 0.0 | 8.1 ± 0.3 | 16.8 ± 0.6 | 15.6 ± 0.8 | 13.6 ± 2.0 |
| Control (solvent) | - * | - * | - * | - * | - * | - * |
3.2. Microbial Growth Inhibition by Low-Concentration Essential Oils
3.2.1. Antifungal Activity
3.2.2. Antibacterial Activity
3.3. Interference of Low-Concentration Essential Oils with Stone Materials
3.4. Interference Tests of Low-Concentration Essential Oils on Pigments
4. Discussion
5. Conclusions
Author Contributions
Funding
Institutional Review Board Statement
Informed Consent Statement
Data Availability Statement
Acknowledgments
Conflicts of Interest
References
- Urzì, C.; Bruno, L.; De Leo, F. Biodeterioration of paintings in caves, catacombs and other hypogean sites. In Biodeterioration and Preservation in Art, Archaeology and Architecture; Mitchell, R., Clifford, J., Eds.; Archetype Publications: London, UK, 2018; pp. 114–129. [Google Scholar]
- Gavish-Regev, E.; Aharon, S.; Armiach Steinpress, I.; Seifan, M.; Lubin, Y. A primer on spider assemblages in Levantine caves: The neglected substerranean habitats of the Levant—A biodiversity mine. Diversity 2021, 13, 179. [Google Scholar] [CrossRef]
- Albertano, P.; Urzì, C. Structural interactions among epilithic cyanobacteria and heterotrophic microorganisms in Roman Hypogea. Microb. Ecol. 1999, 38, 244–252. [Google Scholar] [CrossRef] [PubMed]
- Urzì, C.; De Leo, F.; Krakova, L.; Pangallo, D.; Bruno, L. Effects of biocide treatments on the biofilm community in Domitilla’s catacombs in Rome. Sci. Total Environ. 2016, 572, 252–262. [Google Scholar] [CrossRef]
- Albertano, P. Epilithic algal communities in hypogean environments. Plant Biosyst. 1993, 127, 386–392. [Google Scholar] [CrossRef]
- Lee, M.Y.; Kim, D.W.; Chung, Y.J. Conservation environmental assessment and microbial distribution of the Songsan-ri ancient tombs, Gonju, Korea. J. Conserv. Sci. 2014, 30, 169–179. [Google Scholar] [CrossRef]
- Isola, D.; Zucconi, L.; Cecchini, A.; Caneva, G. Dark-pigmented biodeteriogenic fungi in Etruscan hypogeal tombs: New data on their culture dependent diversity, favouring conditions, and resistance to biocidal treatments. Fungal Biol. 2021, 125, 609–620. [Google Scholar] [CrossRef] [PubMed]
- Ciferri, O. Microbial degradation of paintings. Appl. Environ. Microbiol. 1999, 65, 879–885. [Google Scholar] [CrossRef]
- Caneva, G.; Isola, D.; Lee, H.J.; Chung, Y.J. Biological risk for hypogea: Shared data from Etruscan tombs in Italy and ancient tombs of the Baekje dynasty in Republic of Korea. Appl. Sci. 2020, 10, 6104. [Google Scholar] [CrossRef]
- SchabereiteR-Gurtner, C.; Sáiz-Jiménez, C.; Piñar, G.; Lubitz, W.; Rölleke, S. Culture-independent analyses of bacterial communities on paleolithic paintings and surrounding rock walls in karstic caves Altamira, Tito Bustillo, La Garma and Llonín. In Proceedings of the Coalition Workshop: Sustainable Conservation: An European Concern, Florence, Italy, 7 November 2002. [Google Scholar]
- Zhou, X.H.; Xie, H.R.; Pei, Y.; Liu, W.J.; Hokoi, S.; Li, Y.H. Effects of different light wavelengths on mold growth in tomb. J. Phys. Conf. Ser. 2021, 2069, 012014. [Google Scholar] [CrossRef]
- Sakr, A.A.; Ali, M.F.; Farouk Ghaly, M.; Farrag Abdel-Haliem, M.E.S. Discoloration of ancient Egyptian mural paintings by Streptomyces strains and methods of its removal. Int. J. Conserv. Sci. 2012, 3. [Google Scholar]
- Sakr, A.A.; Ghaly, M.F.; Hela, G.E.; Haliem, M.E.A. Effect of thymol against fungi deteriorating mural paintings at Tell Basta Tombs, Lower Egypt. Int. J. Res. Stud. Biosci. 2018, 6, 8–23. [Google Scholar]
- Unković, N.; Ljaljević Grbić, M.; Subakov-Simić, G.; Stupar, M.; Vukojević, J.; Jelikić, A.; Stanojević, D. Biodeteriogenic and toxigenic agents on 17th century mural paintings and façade of the old church of the Holy Ascension (Veliki Krčimir, Serbia). Indoor Built Environ. 2015, 25, 826–837. [Google Scholar] [CrossRef]
- Kiyuna, T.; An, K.D.; Kigawa, R.; Sano, C.; Miura, S.; Sugiyama, J. Molecular assessment of fungi in “black spots” that deface murals in the Takamatsuzuka and Kitora Tumuli in Japan: Acremonium sect. Gliomastix including Acremonium tumulicola sp. nov. and Acremonium felinum comb. nov. Mycoscience 2011, 52, 1–17. [Google Scholar] [CrossRef]
- Abdel-Haliem, M.E.F.; Sakr, A.A.; Ali, M.F.; Ghaly, M.F.; Sohlenkamp, C. Characterization of Streptomyces isolated causing colour changes of mural paintings in ancient Egyptian tombs. Microbiol. Res. 2013, 168, 428–437. [Google Scholar] [CrossRef]
- Sakr, A.A.; Ghaly, M.F.; Ali, M.F.; Abdel-Haliem, M.E.F. Biodeterioration of binding media in tempera paintings by Streptomyces isolated from some ancient Egyptian paintings. Afr. J. Biotechnol. 2013, 12, 1644–1656. [Google Scholar]
- Lee, H.J.; Chung, Y.J. Changes in the microbial distribution of Buyeo Royal Tombs: Tomb No. 1. J. Conserv. Sci. 2022, 38, 254–264. [Google Scholar] [CrossRef]
- Lee, H.J.; Chung, Y.J. Optimal growth conditions of microorganisms isolated from the Buyeo Royal Tomb No. 1 and their effects on painting layers. Adv. Microbiol. 2022, 12, 525–540. [Google Scholar] [CrossRef]
- Maillard, J.Y. Antimicrobial biocides in the healthcare environment: Efficacy, usage, policies, and perceived problems. Ther. Clin. Risk Manag. 2005, 1, 307. [Google Scholar]
- Fernandes, P. Applied microbiology and biotechnology in the conservation of cultural heritage materials. Appl. Microbiol. Biotechnol. 2006, 73, 291–296. [Google Scholar] [CrossRef]
- Palla, F.; Bruno, M.; Mercurio, F.; Tantillo, A.; Rotolo, V. Essential oils as natural biocides in conservation of cultural heritage. Molecules 2020, 25, 730. [Google Scholar] [CrossRef]
- Guiamet, P.S.; Gómez de Saravia, S.G.; Arenas, P.; Pérez, M.L.; De la Paz, J.; Borrego, S.F. Natural products isolated from plants used in biodeterioration control. Pharmacologyonline 2006, 3, 537–544. [Google Scholar]
- Fidanza, M.R.; Caneva, G. Natural biocide for the conservation of stone cultural heritage: A review. J. Cult. Herit. 2019, 38, 271–286. [Google Scholar] [CrossRef]
- Marcotte, S.; Estel, L.; Leboucher, S.; Minchin, S. Occurrence of organic biocide in the air and dust at the Natural History Museum of Rouen, France. J. Cult. Herit. 2013, 15, 68–72. [Google Scholar] [CrossRef]
- Kigawa, R.; Sano, C.; Kiyuna, T.; Tazato, N.; Sugiyama, J. Use of ethanol, and isopropanol as carbon sources by microorganisms isolated from Takamatsuzuka and Kitora tumuli. Sci. Conserv. 2010, 49, 231–238. [Google Scholar]
- Bastian, F.; Alabouvette, C. Light and shadow on the conservation of a rock art cave: The case of Lascaux cave. Int. J. Speleol. 2008, 38, 6. [Google Scholar] [CrossRef]
- Bastian, F.; Alabouvette, C.; Jurado, V.; Saiz-Jimenz, C. Impact of biocide treatments on the bacterial communities of the Lascaux Cave. Naturwissenschaften 2009, 96, 863–868. [Google Scholar] [CrossRef]
- Caneva, G.; Chung, Y.J. Biological risk for hypogea: A review from international literature and new contributions. In Biological Risk for Hypogea—Shared Data among Italy and Republic of Korea; Caneva, G., Chung, Y.J., Eds.; Nardini Editore: Florence, Italy, 2021; pp. 15–30. [Google Scholar]
- National Research Foundation of Korea. Research of Conservation Environment and Eco-Friendly Damage Control of Cultural Heritage Korea and Italy; Research Foundation of Korea: Buyeo, Republic of Korea, 2019; pp. 1–83.
- Bartolini, M.; Pietrini, A.M.; Ricci, S. Valutazione dell’efficacia di alcuni nuovi biocidi per il trattamento di microflora fotosintetica e di briofite su materiali lapidei. Boll. Per Il Restauro 2007, 14, 101–111. [Google Scholar]
- Nugari, M.P.; Salvadori, O. Biocdies and treatment of stone: Limitation and future prospects. In Art, Biology and Conservation: Biodeterioration of Works of Art; Koestler, R.J., Koestler, V.H., Charola, E.A.E., Nieto-Fernandex, F.E., Eds.; The Metropolitan Museum of Art: New York, NY, USA, 2003; pp. 518–535. [Google Scholar]
- Koestler, R.J.; Salvadori, O. Methods of evaluating biocides for the conservation of porous building materials. Sci. Technol. Cult. Herit. 1996, 5, 63–68. [Google Scholar]
- Jeong, S.H.; Lee, H.J.; Chung, Y.J. New biocide for eco-friendly biofilm removal on outdoor stone monuments. Int. Biodeter. Biodeg. 2018, 131, 19–28. [Google Scholar] [CrossRef]
- Caneva, G.; Tescari, M. Stone biodeterioration: Treatments and preventive conservation. In Proceedings of the 2017 International Symposium of Stone Conservation—Conservation Technologies for Stone Cultural Heritages: Status and Future Prospects, National Research Institute of Cultural Heritage, Daejeon, Republic of Korea, 21 September 2017. [Google Scholar]
- Hanchem. Development of Functions and Application Technology of Insect Repellent and Antimicrobial ‘BOZONE’ Product; KNUCH: Buyeo, Republic of Korea, 2018; pp. 1–188. [Google Scholar]
- Arjmand, Z.; Dastan, D. Chemical characterization and biological activity of essential oils from the aerial part and root of Ferula haussknechtii. Flavour. Fragr. J. 2020, 35, 112–114. [Google Scholar] [CrossRef]
- Bakkali, F.; Averbeck, S.; Averbeck, D.; Idaomar, M. Biological effects of essential oils—A review. Food Chem. Toxicol. 2008, 46, 446–475. [Google Scholar] [CrossRef] [PubMed]
- Rotolo, V.; Barresi, G.; Di Carlo, E.; Giordano, A.; Lombardo, G.; Crimi, E.; Costa, E.; Bruno, M.; Palla, F. Plant extracts as green potential strategies to control the biodeterioration of cultural heritage. Int. J. Conserv. Sci. 2016, 7, 839–846. [Google Scholar]
- Borrego, S.; Valés, O.; Vivar, I.; Lavin, P.; Guiamet, P.; Battistoni, P.; Saravia, S.G.D.; Borges, P. Essential oils of plants as biocides against microorganisms from Cuban and Argentine documentary heritage. Int. Sch. Res. Netw. 2012, 2012, 826786. [Google Scholar] [CrossRef]
- Geweely, N.S.; Afifi, H.A.; Ibrahim, D.M.; Solima, M.M. Efficacy of essential oils on fungi isolated from archaeological objects in Saqquara Excavation, Egypt. Geomicrobiol. J. 2019, 36, 148–168. [Google Scholar] [CrossRef]
- Argyri, A.A.; Doulgeraki, A.I.; Varla, E.G.; Bikouli, V.C.; Natskoulis, P.I.; Haroutounian, S.A.; Moulas, G.A.; Tassou, C.C.; Chorianopoulos, N.G. Evaluation of plant origin essential oils as herbal biocides for the protection of caves belonging to natural and cultural heritage sites. Microorganisms 2021, 9, 1836. [Google Scholar] [CrossRef] [PubMed]
- Lee, H.J.; Chung, Y.J. Preliminary in vitro antimicrobial activity trials on selected microorganisms threatening the ancient tomb No. 1 in Neungsan-ri, Buyeo (Republic of Korea), In Biological Risk for Hypogea—Shared Data among Italy and Republic of Korea; Caneva, G., Chung, Y.J., Eds.; Nardini Editore: Florence, Italy, 2021; pp. 71–80. [Google Scholar]
- Research Institute of Cultural Heritage. The Tomb Murals in South Korea; Research Institute of Cultural Heritage: Mokpo, Republic of Korea, 2019; pp. 10–17.
- Park, J.H.; Lee, G.H.; Lee, C.H. Consideration for historical application of augen gneiss and petrographic characteristics for rock properties of Donghachong Tomb from Royal Tombs of Neungsanri in Buyeo, Korea. Econ. Environ. Geol. 2019, 52, 91–106. [Google Scholar]
- Korea National University of Cultural Heritage. Investigation of the Conservation Environment of the Ancient Tomb Donghachong in Neungsan-ri; KNUCH: Buyeo, Republic of Korea, 2008; pp. 1–334. [Google Scholar]
- Lee, S.O.; Bae, G.W.; Namgung, H.; Nam, D.H.; Choi, Y.G.; Chung, K.Y. Conservation state of mural paintings of Royal Tombs in Neungsan-ri, Korea. J. Conserv. Sci. 2018, 34, 333–343. [Google Scholar] [CrossRef]
- Buyeogun and Backje World Heritage Center. Monitoring the Conservation Environment of the Ancient Tombs in Neungsan-ri; KNUCH: Buyeo, Republic of Korea, 2016; pp. 1–139. [Google Scholar]
- Korea National University of Cultural Heritage. Continuous Monitoring of Donghachong of the Ancient Tombs in Neungsan-ri; Buyeogun and Backje World Heritage Center: Buyeo, Republic of Korea, 2018; pp. 1–171. [Google Scholar]
- Martí, M.; Frígols, B.; Serrano-Aroca, A. Antimicrobial characterization of advanced materials for bioengineering applications. J. Vis. Exp. 2018, 138. [Google Scholar] [CrossRef]
- Kim, B.A. Development of cosmetics preservative using natural essential oil. J. Converg. Inf. Technol. 2019, 5, 445–450. [Google Scholar]
- Chemicals Information System. National Institute of Environmental Research. Available online: http://ncis.nier.go.kr (accessed on 13 January 2023).
- Chung, Y.J.; Seo, M.S.; Lee, K.S.; Hwang, J.J. A Study of Cleaning on the Biofilm of Stone Cultural Properties. In Conservation Science Studies; National Research Institute of Cultural Heritage: Daejeon, Republic of Korea, 2005; pp. 5–25. [Google Scholar]
- Korea National University of Cultural Heritage. Research of Conservation Environment and Eco-Friendly Damage Control of Cultural Heritage Korea and Italy; Research Foundation of Korea: Buyeo, Republic of Korea, 2020; pp. 1–57.
- Pinna, D. Coping with Biological Growth on Stone Heritage Objects: Methods, Products, Applications, and Perspective; Apple Academic Press: New York, NY, USA, 2017; p. 382. [Google Scholar]
- Lee, H.J. Growth Characteristics and Control Methods of the Microorganisms in Mural Tombs: A focused Study of the Tomb No. 1 in Neungsan-ri. Buyeo. Ph.D. Thesis, Korea National University of Cultural Heritage, Buyeo, Republic of Korea, August 2021. [Google Scholar]
- Stupar, M.; Grbić, M.L.; Džamić, A.; Unković, N.; Ristić, M.; Jelikić, A.; Vukojević, J. Antifungal activity of selected essential oils and biocide benzalkonium chloride against the fungi isolated from cultural heritage objects. S. Afr. J. Bot. 2014, 93, 118–124. [Google Scholar] [CrossRef]
- Pop, D.M.; Timar, M.C.; Varodi, A.M. Comparative assessment of the biocidal potential of 3 essential oils. Bull. Transilv. Univ. Bras. II Wood Ind. Agric. Food. Eng. 2019, 12, 83–96. [Google Scholar] [CrossRef]
- Baghdady, K.Z.; Tolba, S.T.; Houssien, S.S. Biogenic deterioration of Egyptian limestone monuments: Treatment and conservation. J. Cult. Herit. 2019, 38, 118–125. [Google Scholar] [CrossRef]
- El-Sayed, H.S.; Chizzola, R.; Ramadan, A.A.; Edris, A.E. Chemical composition and antimicrobial activity of garlic essential oils evaluated in organic solvent, emulsifying, and self-microemulsifying water based delivery systems. Food Chem. 2017, 221, 196–204. [Google Scholar] [CrossRef] [PubMed]
- Albasil, M.D.; Abeer EIHagrassy, G.M.; Reyad, A.M. Evaluating the antimicrobial activity of essential oils in the conservation of mural paintings. Conserv. Sci. Cult. Herit. 2021, 21, 125–148. [Google Scholar]
- Sanmartín, P.; Carballeira, R. Changes in heterotrophic microbial communities induced by biocidal treatments in the Monastery of San Martiño Pinario, Santiago de Compostela, NW Spain. Int. Biodeterior. Biodegrad. 2021, 156, 105130. [Google Scholar] [CrossRef]
- Hanchem. Development of Functions and Application Technology of Insect Repellent and Antimicrobial ‘BOZONE’ Product; KNUCH: Buyeo, Republic of Korea, 2021; pp. 1–295. [Google Scholar]

| Source of EO | Scientific Name | Extraction Method | Manufacturer |
|---|---|---|---|
| Eucalyptus | Eucalyptus globulus | Steam-distilled from leaves and small branches | Code 7545, Now Foods, Bloomingdale, IL, USA |
| Lavender | Lavendula angustifolia | Steam-distilled from flowering tops | Code 7560TL, Now Foods, Bloomingdale, IL, USA |
| Tea tree | Melaleuca alternifolia | Steam-distilled from leaves and twigs | Code 7625TL, Now Foods, Bloomingdale, IL, USA |
| Peppermint | Mentha piperita | Steam-distilled from aerial parts | Code 7585, Now Foods, Bloomingdale, IL, USA |
| Oregano | Origanum vulgare | Steam-distilled from dried flowering herb | Code 7494, Now Foods, Bloomingdale, IL, USA |
| Rosemary | Rosmarinus officinalis | Steam-distilled from tops of the plant | Code 7600, Now Foods, Bloomingdale, IL, USA |
| Clove bud | Syzygium aromaticum | Steam-distilled from the flower bud | What Soap, Korea |
| Thyme | Thymus vulgaris | Steam-distilled from the flower and leaves | What Soap, Korea |
| Grapefruit | Citrus paradisi | Cold-pressed from fresh fruit peel | Code 7553, Now Foods, Bloomingdale, IL, USA |
| Basil | Ocimum basilicum | Steam-distilled from the leaves | Code 7516, Now Foods, Bloomingdale, IL, USA |
| Cinnamon cassia | Cinnamomum cassia | Steam-distilled from the dried inner bark | Code 7530, Now Foods, Bloomingdale, IL, USA |
| Source of EO | Strains | Inhibition Zone (mm) | ||||||
|---|---|---|---|---|---|---|---|---|
| 1% | 3% | 5% | 7.5% | 10% | Controls † | |||
| Distilled Water | Solvent | |||||||
| Oregano | F1 | - * | - * | - * | 1.2 ± 0.5 | 2.0 ± 0.7 | - * | - * |
| F2 | - * | - * | 5.8 ± 0.0 | 5.8 ± 0.0 | 5.8 ± 0.0 | - * | - * | |
| B1 | - * | - * | 0.2 ± 0.2 | 3.2 ± 0.6 | 3.3 ± 1.5 | - * | - * | |
| B2 | - * | 1.3 ± 0.1 | 3.3 ± 1.2 | 7.5 ± 0.4 | 9.2 ± 1.6 | - * | - * | |
| B3 | - * | - * | 2.1 ± 0.5 | 5.1 ± 1.7 | 5.9 ± 2.3 | - * | - * | |
| B4 | - * | 0.3 ± 0.3 | 4.8 ± 2.3 | 7.0 ± 1.4 | 7.8 ± 1.9 | - * | - * | |
| Clove bud | F1 | - * | - * | - * | - * | - * | - * | - * |
| F2 | - * | - * | - * | - * | - * | - * | - * | |
| B1 | - * | - * | - * | - * | 0.3 ± 0.0 | - * | - * | |
| B2 | - * | - * | 0.4 ± 0.1 | 1.3 ± 0.5 | 3.3 ± 0.2 | - * | - * | |
| B3 | - * | - * | 0.1 ± 0.1 | 0.5 ± 0.2 | 0.8 ± 0.5 | - * | - * | |
| B4 | - * | - * | - * | 0.5 ± 0.2 | 0.9 ± 0.1 | - * | - * | |
| Thyme | F1 | - * | - * | - * | - * | 0.3 ± 0.0 | ||
| F2 | - * | - * | - * | - * | 0.2 ± 0.1 | |||
| B1 | - * | - * | - * | - * | 0.3 ± 0.2 | - * | - * | |
| B2 | - * | - * | 0.8 ± 0.0 | 1.3 ± 0.2 | 1.5 ± 0.2 | - * | - * | |
| B3 | - * | - * | - * | 0.0 ± 0.1 | 0.3 ± 0.1 | - * | - * | |
| B4 | - * | - * | - * | 0.4 ± 0.1 | 0.8 ± 0.2 | - * | - * | |
| Cinnamon cassia | F1 | - * | 0.3 ± 0.0 | 0.5 ± 0.0 | 0.8 ± 0.2 | 1.0 ± 0.0 | - * | - * |
| F2 | - * | - * | 5.8 ± 0.0 | 5.8 ± 0.0 | 5.8 ± 0.0 | - * | - * | |
| B1 | - * | 1.2 ± 0.1 | 2.6 ± 0.3 | 3.7 ± 0.5 | 3.9 ± 0.1 | - * | - * | |
| B2 | - * | 2.2 ± 0.1 | 3.3 ± 0.1 | 4.3 ± 0.4 | 4.6 ± 0.1 | - * | - * | |
| B3 | - * | 3.2 ± 0.2 | 4.9 ± 0.5 | 6.5 ± 0.5 | 7.6 ± 1.0 | - * | - * | |
| B4 | - * | 2.1 ± 0.5 | 4.1 ± 0.8 | 5.7 ± 0.6 | 7.1 ± 1.4 | - * | - * | |
| Source of EO | Concentration | Rate of Weight Change (%) | |
|---|---|---|---|
| Granite | Gneiss | ||
| Oregano | 1% | 0.04 ± 0.02 | 0.06 ± 0.03 |
| 3% | 0.05 ± 0.02 | 0.32 ± 0.19 | |
| 5% | 0.06 ± 0.04 | 0.03 ± 0.01 | |
| 7.5% | 0.26 ± 0.13 | 0.04 ± 0.01 | |
| 10% | 0.05 ± 0.02 | 0.04 ± 0.00 | |
| Clove bud | 1% | 0.97 ± 0.07 | 0.05 ± 0.02 |
| 3% | 0.69 ± 0.33 | 0.49 ± 0.25 | |
| 5% | 0.22 ± 0.23 | 0.83 ± 0.56 | |
| 7.5% | 0.46 ± 0.18 | 0.66 ± 0.29 | |
| 10% | 0.77 ± 0.60 | 0.32 ± 0.09 | |
| Thyme | 1% | 0.09 ± 0.07 | 0.09 ± 0.10 |
| 3% | 1.19 ± 0.34 | 0.03 ± 0.01 | |
| 5% | 0.07 ± 0.02 | 0.04 ± 0.00 | |
| 7.5% | 0.43 ± 0.09 | 0.06 ± 0.04 | |
| 10% | 0.15 ± 0.08 | 0.10 ± 0.05 | |
| Cinnamon cassia | 1% | 0.07 ± 0.02 | 0.04 ± 0.02 |
| 3% | 0.08 ± 0.01 | 0.08 ± 0.04 | |
| 5% | 0.07 ± 0.02 | 0.06 ± 0.04 | |
| 7.5% | 0.11 ± 0.02 | 0.34 ± 0.18 | |
| 10% | 0.19 ± 0.19 | 0.41 ± 0.18 | |
| Control 2 (Solvent) | 0.04 ± 0.01 | 0.03 ± 0.00 | |
| Control 1 (Distilled water) | 0.09 ± 0.04 | 0.11 ± 0.02 | |
Disclaimer/Publisher’s Note: The statements, opinions and data contained in all publications are solely those of the individual author(s) and contributor(s) and not of MDPI and/or the editor(s). MDPI and/or the editor(s) disclaim responsibility for any injury to people or property resulting from any ideas, methods, instructions or products referred to in the content. |
© 2023 by the authors. Licensee MDPI, Basel, Switzerland. This article is an open access article distributed under the terms and conditions of the Creative Commons Attribution (CC BY) license (https://creativecommons.org/licenses/by/4.0/).
Share and Cite
Lee, H.-J.; Chung, Y.-J. Antifungal, Antibacterial, and Interference Effects of Plant-Extracted Essential Oils Used for Mural Conservation at Buyeo Royal Tomb No. 1. Appl. Sci. 2023, 13, 3645. https://doi.org/10.3390/app13063645
Lee H-J, Chung Y-J. Antifungal, Antibacterial, and Interference Effects of Plant-Extracted Essential Oils Used for Mural Conservation at Buyeo Royal Tomb No. 1. Applied Sciences. 2023; 13(6):3645. https://doi.org/10.3390/app13063645
Chicago/Turabian StyleLee, Hyun-Ju, and Yong-Jae Chung. 2023. "Antifungal, Antibacterial, and Interference Effects of Plant-Extracted Essential Oils Used for Mural Conservation at Buyeo Royal Tomb No. 1" Applied Sciences 13, no. 6: 3645. https://doi.org/10.3390/app13063645
APA StyleLee, H.-J., & Chung, Y.-J. (2023). Antifungal, Antibacterial, and Interference Effects of Plant-Extracted Essential Oils Used for Mural Conservation at Buyeo Royal Tomb No. 1. Applied Sciences, 13(6), 3645. https://doi.org/10.3390/app13063645
